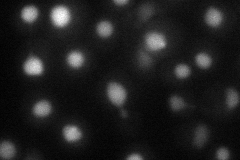
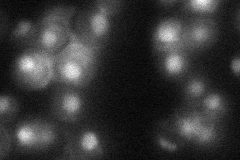

View description
Largest subunit (p90) of the Chromatin Assembly Complex (CAF-1) with Cac2p and Msi1p that assembles newly synthesized histones onto recently replicated DNA; involved in the maintenance of transcriptionally silent chromatin
Localization:
Intensity:
Fold change:
Significance:
-
C’ GFP library in SD

below threshold14.72 -
N' NOP1pr-GFP in SD

nucleus57.4547 -
N' TEF2pr-mCherry in SD
nucleus36.4457 -
N' NATIVEpr-GFP in SD
nucleus23.0349 -
N' TEF2pr-VC and Cyto-VN in SD

nucleus32.0911 -
C’ GFP library in SD+DTT

cytosol16.521.12No -
C’ GFP library in SD+H2O2

cytosol14.91.01No -
C’ GFP library in Starvation Media

cytosol17.571.19No -
C’ GFP library on the background of Pup2-DaMP

below threshold -
C’ GFP library on the background of CCT mutant

below threshold16.67361.1325No
